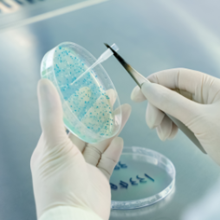

昆虫杆状病毒表达服务
昆虫杆状病毒表达是利用携带有外源目的基因的重组杆状病毒作载体,在昆虫体内或其培养细胞内进行表达的一个重组蛋白生产系统,重组蛋白具有完整的生物学功能,翻译后的修饰:糖基化、磷酸化、酰基化、信号肽切除等,比较接近哺乳动物细胞,采用p10, pH强启动子,具有很高的表达水平,能容纳大分子的插入片段,同时表达多个基因。佰翱得团队有十多年丰富的蛋白表达经验,累计成功完成9000+批次的蛋白表达服务。
服务内容
• 杆状病毒制备(Bac to Bac系统、Bacmam系统);
• 病毒滴度测定;
• Sf9、Sf21、High-5细胞的表达优化(小试表达纯化、FSEC);
• 昆虫细胞悬浮培养大规模表达(1200L/月)。
服务流程
-

![]()
Bacmid 制备3天
-

![]()
Bacmid-P1 10天
-

![]()
病毒滴度测定2天
-

![]()
10ml表达小试3-4天
-

![]()
大量表达2-3天
仪器设备
-
摇床

![]()
-
15L生物反应器

![]()
-
SH800S流式细胞仪

![]()
-
WAVE

![]()

蛋白表达
蛋白表达

